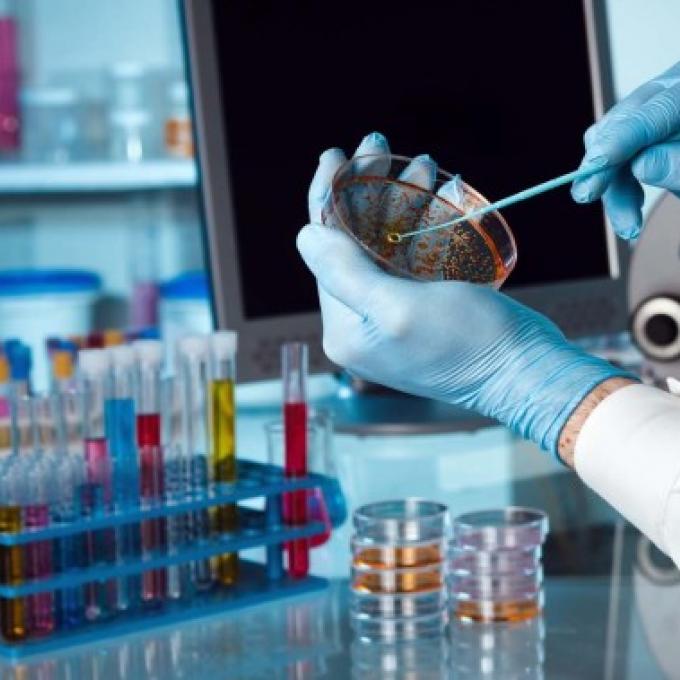

Ένοπλες Δυνάμεις
Πεσόντες Πρώτου Παγκοσμίου Πολέμου: Βρες τον Ήρωα Συγγενή σου!
Παρασκευή, 2 Ιουνίου, 2017Τουρκική κορβέτα επιχείρησε να εμβολίσει την φρεγάτα «ΝΑΒΑΡΙΝΟ» με την ηγεσία του ΠΝ!
Παρασκευή, 2 Ιουνίου, 2017 Ο Ρώσος πρόεδρος Βλαντίμιρ Πούτιν, δήλωσε σήμερα ότι η Ρωσία είναι έτοιμη να πουλήσει στην Τουρκία τα προηγμένης τεχνολογίας
Στρατιωτικό ελικόπτερο, το οποίο μετέφερε 13 στρατιώτες, ορισμένοι εκ των οποίων ήταν υψηλόβαθμοι,
Τα προϊόντα Campingaz® δημιουργήθηκαν από την αγάπη για κάμπινγκ και υπαίθριες δραστηριότητες, σε συνδυασμό με την επιθυμία